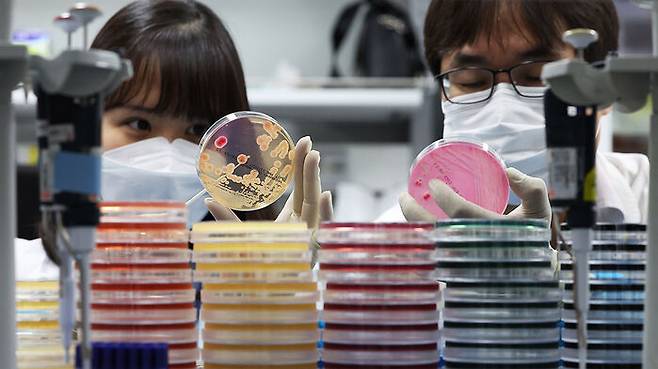

"같은 음식 먹고 2명 이상 설사하면 보건소에 신고하세요"
전체 맥락을 이해하기 위해서는 본문 보기를 권장합니다.
기온이 오르면서 식중독 발생 위험이 커지고 있습니다.
같은 음식을 먹은 뒤 2명 이상 설사·구토 등의 증상을 보이면 즉시 보건소에 신고해야 합니다.
지영미 질병청장은 "집단발생 시 신속한 대응을 위해 2인 이상 설사, 구토 등이 나타나면 가까운 보건소에 즉시 신고해 달라"고 강조하며 "예방을 위해서는 물 끓여 먹기, 음식 익혀 먹기, 흐르는 물에 비누로 30초 이상 손 씻기 등 기본적인 감염병 예방수칙 준수가 중요하다"고 당부했습니다.
이 글자크기로 변경됩니다.
(예시) 가장 빠른 뉴스가 있고 다양한 정보, 쌍방향 소통이 숨쉬는 다음뉴스를 만나보세요. 다음뉴스는 국내외 주요이슈와 실시간 속보, 문화생활 및 다양한 분야의 뉴스를 입체적으로 전달하고 있습니다.
기온이 오르면서 식중독 발생 위험이 커지고 있습니다.
같은 음식을 먹은 뒤 2명 이상 설사·구토 등의 증상을 보이면 즉시 보건소에 신고해야 합니다.
질병관리청은 물이나 음식물의 세균이나 미생물에 의한 수인성·식품매개 감염병 발생 가능성이 높아지면서 내달 1일부터 10월 12일까지 '하절기 비상방역체계'를 운영한다고 오늘(30일) 밝혔습니다.
날씨가 따뜻해지는 데다 가정의 달을 맞아 단체모임과 국내·외 여행이 늘어나면서 수인성·식품매개 감염병이 집단 발생하는 사례가 많아질 수 있다고 질병청은 경고했습니다.

지난해 수인성·식품매개 감염병 집단발생 건수는 529건, 환자는 1만2천94명이었습니다.
2019년부터 2023년까지 5년 평균 479건, 7천801명 대비 각각 10.4%, 55.0% 증가했습니다.
질병청은 수인성·식품매개 감염병을 조기에 인지하고 집단발생 시 신속히 대응할 수 있도록 전국 시도 및 시군구 보건소와 함께 비상근무를 실시할 방침입니다.
지방자치단체는 평일 오전 9시부터 오후 8시, 주말·공휴일은 오후 4시까지 비상근무를 실시하고 그 외 시간에는 비상연락체계를 유지합니다.
질병청은 신속한 대응을 위해 24시간 종합상황실을 운영하기로 했습니다.
지영미 질병청장은 "집단발생 시 신속한 대응을 위해 2인 이상 설사, 구토 등이 나타나면 가까운 보건소에 즉시 신고해 달라"고 강조하며 "예방을 위해서는 물 끓여 먹기, 음식 익혀 먹기, 흐르는 물에 비누로 30초 이상 손 씻기 등 기본적인 감염병 예방수칙 준수가 중요하다"고 당부했습니다.
(사진=질병관리청 제공, 연합뉴스)
유영규 기자 sbsnewmedia@sbs.co.kr
Copyright © Copyright ⓒ SBS. All rights reserved. 무단 전재, 재배포 및 AI학습 이용 금지
- 홍석천, 아들 커밍아웃한 윤여정에 "놀라고 감동받고 위로받아"
- '너의 연애' 리원, 3년 간 BJ활동 인정..."레즈비언은 맞아"
- 해외여행 계획은 4%에 불과…황금연휴, 뭐 하는지 봤더니
- "이 도시락이 1만 2천 원?"…'충주맨' 직접 사과했다
- 부모님 앞으로 부가 서비스 '수두룩'…유심 확인하다 '발칵'
- 약 흩어진 채 모델 엎드려…"너무 음울하고 불쾌" 선 넘은 광고
- '도난당한 장물'이었다…'대명률' 보물 지정 취소의 전말
- 목소리까지 감쪽같아…'여장'한 50대 남성, 전국 식당서 무전취식
- 유심 교체하니 티머니 '0원' 됐다…교체 시 주의사항은?
- 부대 출근 전 "사모님 수영 등록 '오픈런'" 폭로